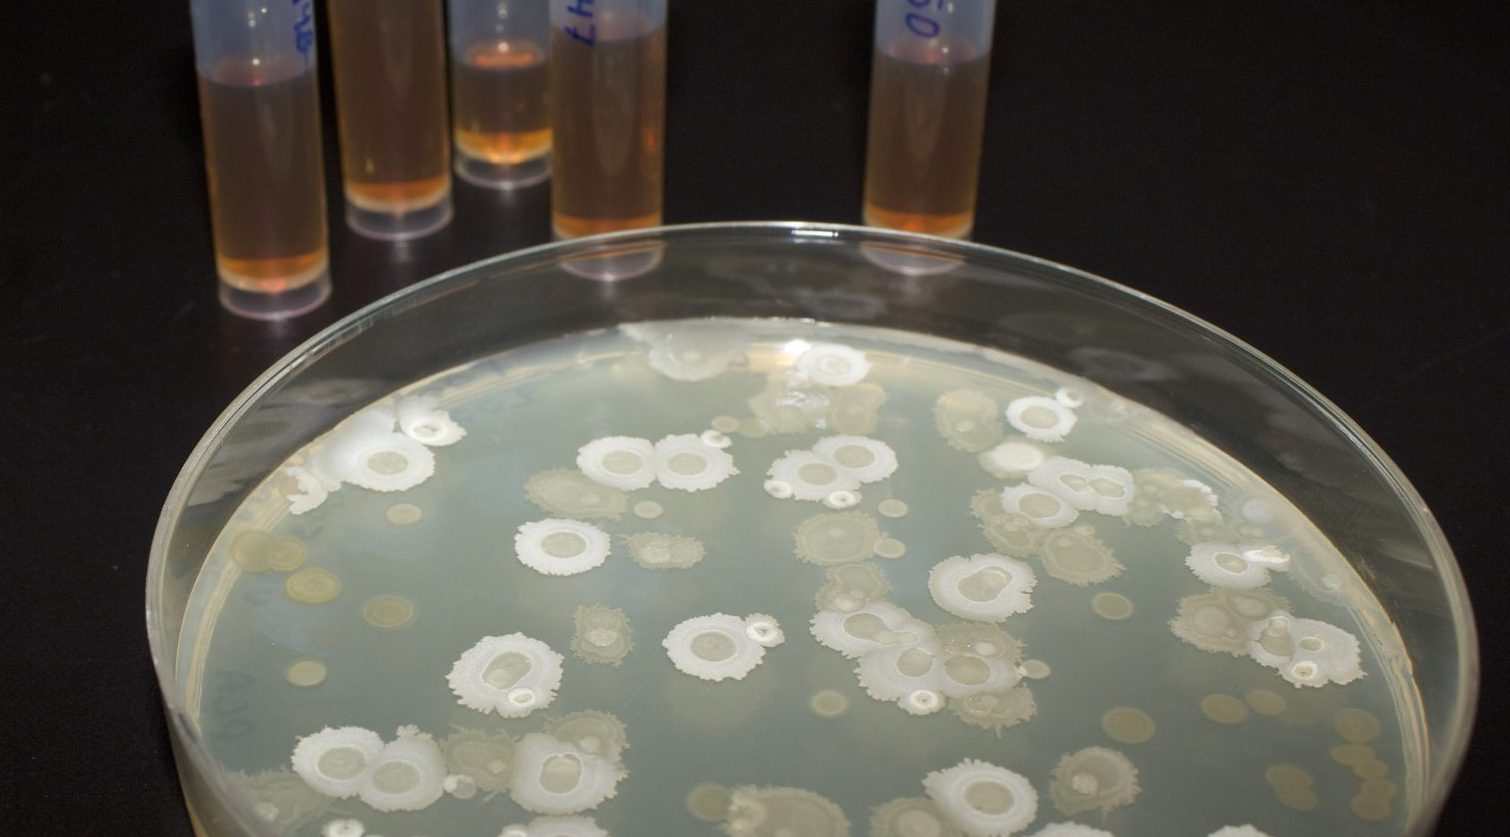

Pousser par la science
Au lieu d’utiliser une seule approche ou mode d’action dans un produit, Ulysse élabore des produits à multiple action soit à base de consortiums bactéries ou via multiple molécule active. Les solutions utilisent donc plusieurs angles d’attaque afin de résoudre les problématiques visées. Nos solutions sont donc plus efficaces et utilisables dans un plus grand spectre d’application. Ulysse maîtrise l'art de créer des consortiums gagnants.

Notre motivation

Notre équipe de passionnés parle d’innovation et de microbiologie comme on parle des meilleurs crus. Assumant nos valeurs, nous voulons jouer un rôle déterminant pour faire face aux grands défis agricoles, sanitaires et médicaux de notre ère. Un rôle de technologie de rupture, permettant d’égaler et de surpasser les résultats offerts par la chimie conventionnelle, de façon naturelle, stable et durable.
Notre science

Invisibles à l’oeil nu, mais générant un impact spectaculaire, les solutions avant-gardistes développées par Ulysse Biotech prouvent à tous que le futur est dans la nature. Et ce n’est que le début: notre équipe a le vent dans les voiles et regarde au-delà de l’horizon en termes d’innovations. Nos experts, mi-scientifiques mi-conquérants, ne craignent pas de refaçonner les modèles existants et de positionner l’entreprise comme un fer de lance dans nos domaines, à l’intersection du progrès environnemental, technologique et humain. Pour tirer le maximum de la force de la nature et faire croître non seulement les récoltes, mais les possibilités de demain.
Nous élaborons des consortiums de bactéries
Ces produits issus d'un travail d'équipe microbien possèdent un grand nombre de caractéristiques avantageuses:
- Une stabilité exceptionnelle de deux ans.
- Une haute précision grâce à la fermentation du type «une bactérie à la fois».
- Une efficacité éprouvée lors d’essais en conditions réelles sur un grand nombre de types de cultures.
- Un produit liquide facile à diluer, sans dépôts et sans aucun agent pathogène.
- Une conception basée sur les besoins de l’utilisateur.